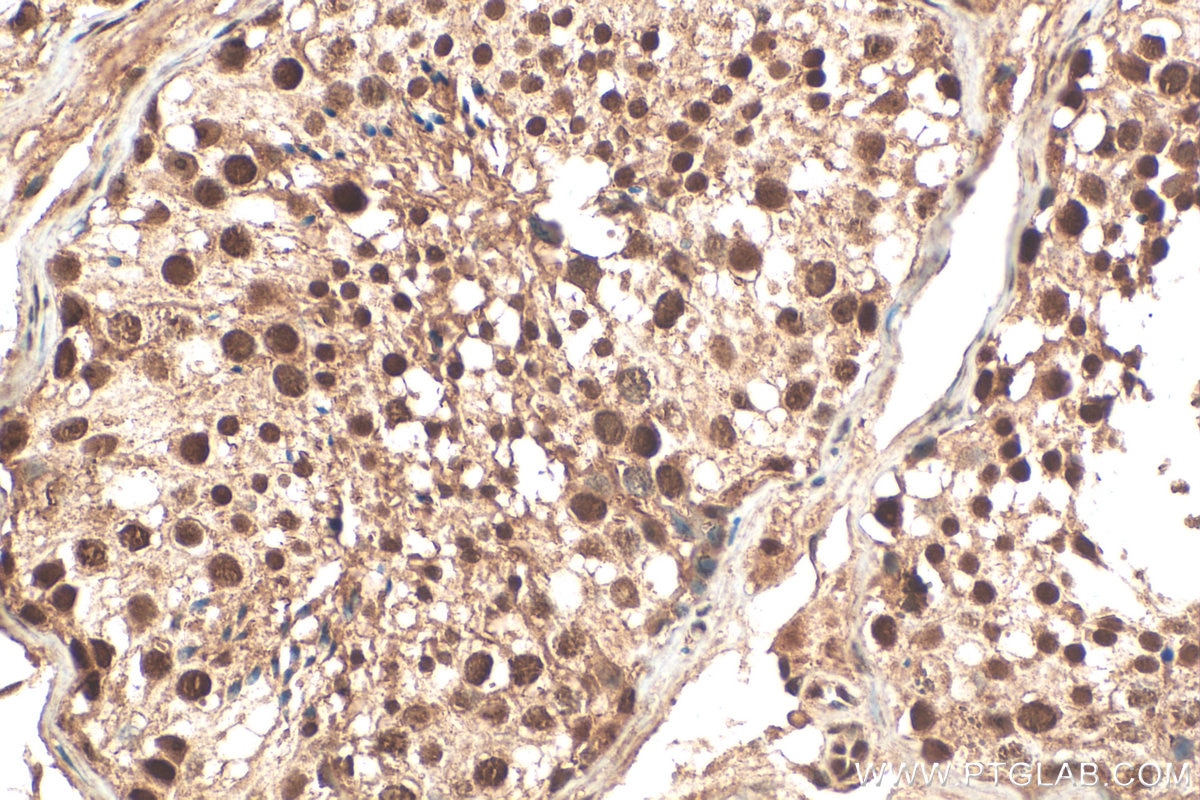
Immunohistochemistry (IHC) staining of human testis tissue using C13orf18 Polyclonal antibody (21183-1-AP)

Validation Data Gallery
Tested Applications
Recommended dilution
| Application | Dilution |
|---|---|
| It is recommended that this reagent should be titrated in each testing system to obtain optimal results. | |
Product Information
21183-1-PBS targets C13orf18 in WB, IHC, IF/ICC, Indirect ELISA applications and shows reactivity with human samples.
| Tested Reactivity | human |
| Host / Isotype | Rabbit / IgG |
| Class | Polyclonal |
| Type | Antibody |
| Immunogen |
CatNo: Ag15474 Product name: Recombinant human C13orf18 protein Source: e coli.-derived, PKG Tag: GST Domain: 1-306 aa of BC032311 Sequence: MVSQSTVRQDSPVEPWEGISDHSGIIDGSPRLLNTDHPPCQLDIRLMRHKAVWINPQDVQQQPQDLQSQVPAAGNSGTHFVTDAASPSGPSPSCLGDSLAETTLSEDTTDSVGSASPHGSSEKSSSFSLSSTEVHMVRPGYSHRVSLPTSPGILATSPYPETDSAFFEPSHLTSAADEGAVQVSRRTISSNSFSPEVFVLPVDVEKENAHFYVADMIISAMEKMKCNILSQQQTESWSKEVSGLLGSDQPDSEMTFDTNIKQESGSSTSSYSGYEGCAVLQVSPVTETRTYHDVKEICKCDVDEFV 相同性解析による交差性が予測される生物種 |
| Full Name | chromosome 13 open reading frame 18 |
| Calculated molecular weight | 662 aa, 73 kDa |
| Observed molecular weight | 66 kDa |
| GenBank accession number | BC032311 |
| Gene Symbol | C13orf18 |
| Gene ID (NCBI) | 80183 |
| RRID | AB_10733098 |
| Conjugate | Unconjugated |
| Form | |
| Form | Liquid |
| Purification Method | Antigen affinity purification |
| UNIPROT ID | Q9H714 |
| Storage Buffer | PBS only{{ptg:BufferTemp}}7.3 |
| Storage Conditions | Store at -80°C. |
Background Information
C13orf18 (also known as Pacer), now formally designated RUBCNL (Rubicon-like autophagy enhancer), is a protein containing an EF-hand calcium-binding domain with potential transporter functions. Initially identified as a candidate tumor suppressor gene, it is frequently silenced in cervical cancer due to promoter hypermethylation. Its re-expression inhibits cervical cancer cell proliferation, suggesting tumor-suppressing activity. Furthermore, research has revealed that polymorphisms in the 3'UTR region of the C13orf18 gene are associated with amyotrophic lateral sclerosis (ALS), suggesting its potential involvement in autophagy regulation and the pathogenesis of neurodegenerative diseases.